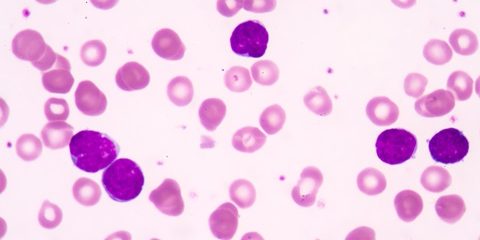

Panel for diagnosis ALL–T Cell
CD1a, CD2, cCD3, CD3, CD4, CD5, CD7, CD8, CD10, CD56, TCRα/β or γ/δ, CD34, HLA-DR, TdT, CD45
پنل تشخیصی برای لوسمی لنفوبلاستیک T سلولی (ALL-T) شامل مجموعهای از مارکرهای سطح سلولی و داخلی است که به شناسایی و تفکیک سلولهای لوکمیایی T-سلولی از سایر انواع سلولهای لوکمیایی و غیرلوکمیایی کمک میکنند. این مارکرها برای تشخیص دقیق، طبقهبندی و پیشبینی پروگنوز بیماری مهم هستند. در زیر به توضیح مختصری در مورد نقش هر یک از این مارکرها در تشخیص ALL-T پرداخته شده است:
CD1a: مارکری است که بر روی سلولهای T در مراحل اولیه تکامل بیان میشود و میتواند به تفکیک زیرگروههای مختلف ALL-T کمک کند.
CD2، CD5، CD7: مارکرهای سطحی هستند که بر روی سلولهای T یافت میشوند و در تشخیص ALL-T نقش دارند.
cCD3 و CD3: cCD3 بیان داخل سلولی است که در سلولهای T پیشساز یافت میشود، در حالی که CD3 بر روی سطح سلولهای T متورم بیان میشود. هر دو برای تشخیص ALL-T مهم هستند.
CD4، CD8: مارکرهایی که نقشهای مختلفی در سیستم ایمنی دارند و میتوانند بر روی سلولهای T لوکمیایی بیان شوند. حضور یا غیاب این مارکرها به طبقهبندی زیرگروههای ALL-T کمک میکند.
CD10: گاهی اوقات در سلولهای T لوکمیایی بیان میشود و میتواند به تفکیک ALL-T از سایر انواع لوسمی کمک کند.
CD56: مارکری که بر روی سلولهای کشنده طبیعی (NK) و برخی از سلولهای T بیان میشود. حضور این مارکر در ALL-T ممکن است نشاندهنده یک فنوتیپ خاص باشد.
TCRα/β یا γ/δ: رسپتورهای سلول T که بر روی سلولهای T متورم بیان میشوند و میتوانند به تفکیک زیرگروههای مختلف ALL-T کمک کنند.
CD34 و HLA-DR: مارکرهایی که ممکن است بر روی سلولهای پیشساز در ALL بیان شوند و به تشخیص و طبقهبندی کمک میکنند.
TdT (Terminal deoxynucleotidyl transferase): آنزیم داخل سلولی که در سلولهای پیشساز لنفوئیدی بیان میشود و به تفکیک ALL از سایر انواع لوسمی و لنفوم کمک میکند.
CD45: به عنوان آنتیژن لکوسیتی مشترک، در تمامی سلولهای لوکمیایی و غیرلوکمیایی بیان میشود و به عنوان یک مارکر پایه برای فلوسایتومتری کاربرد دارد.
استفاده از این پنل فلوسایتومتری امکان تشخیص دقیق ALL-T را فراهم میآورد، که برای تعیین استراتژیهای درمانی مناسب و پیشبینی پروگنوز بیماران مهم است. این دقت در تشخیص میتواند به پزشکان کمک کند تا زیرگروههای مختلف ALL-T را شناسایی کنند و درمانهای هدفمندتری را ارائه دهند.